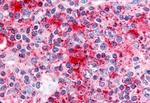
Cdc7 Antibody in Immunohistochemistry (Paraffin) (IHC (P))

Search
Invitrogen
Cdc7 Polyclonal Antibody
{{$productOrderCtrl.translations['antibody.pdp.commerceCard.promotion.promotions']}}
{{$productOrderCtrl.translations['antibody.pdp.commerceCard.promotion.viewpromo']}}
{{$productOrderCtrl.translations['antibody.pdp.commerceCard.promotion.promocode']}}: {{promo.promoCode}} {{promo.promoTitle}} {{promo.promoDescription}}. {{$productOrderCtrl.translations['antibody.pdp.commerceCard.promotion.learnmore']}}
产品信息
PA5-33416
种属反应
宿主/亚型
分类
类型
抗原
偶联物
形式
浓度
规格
纯化类型
保存液
内含物
保存条件
运输条件
RRID
产品详细信息
Percent identity with other species by BLAST analysis: Human, Gorilla, Gibbon, Marmoset, Elephant, Panda, Dog, Bat, Bovine, Horse, Rabbit, Opossum (100%).
靶标信息
CDC7 is a cell division cycle 7 homolog protein that is critical for the G1/S transition and is also essential for initiation of DNA replication as cell division occurs. CDC7 is expressed in many normal tissues, but the overexpression of CDC7 may be associated with neoplastic transformation for some tumors and transformed cell lines. CDC7/DBF4 kinase promotes S phase by alleviating an inhibitory activity in Mcm4 that evolved to integrate several protein kinase. CDC7 encodes a cell division cycle protein with kinase activity that is critical for the G1/S transition. The yeast homolog is also essential for initiation of DNA replication as cell division occurs. Overexpression of this gene product may be associated with neoplastic transformation for some tumors. Multiple alternatively spliced transcript variants that encode the same protein have been detected.
仅用于科研。不用于诊断过程。未经明确授权不得转售。
篇参考文献 (0)
生物信息学
蛋白别名: CDC7 (cell division cycle 7, S. cerevisiae, homolog)-like 1; Cdc7 Kinase; CDC7-like 1; CDC7-related kinase; cell division cycle 7 homolog; cell division cycle 7-like protein 1; Cell division cycle 7-related protein kinase; epididymis secretory sperm binding protein; MGC117361; MGC126237; MGC126238; MGC91067; protein kinase; unnamed protein product
基因别名: CDC7; CDC7L1; HsCDC7; Hsk1; huCDC7
UniProt ID: (Human) O00311
Entrez Gene ID: (Dog) 479955, (Rabbit) 100343407, (Bovine) 516094, (Human) 8317, (Horse) 100060468